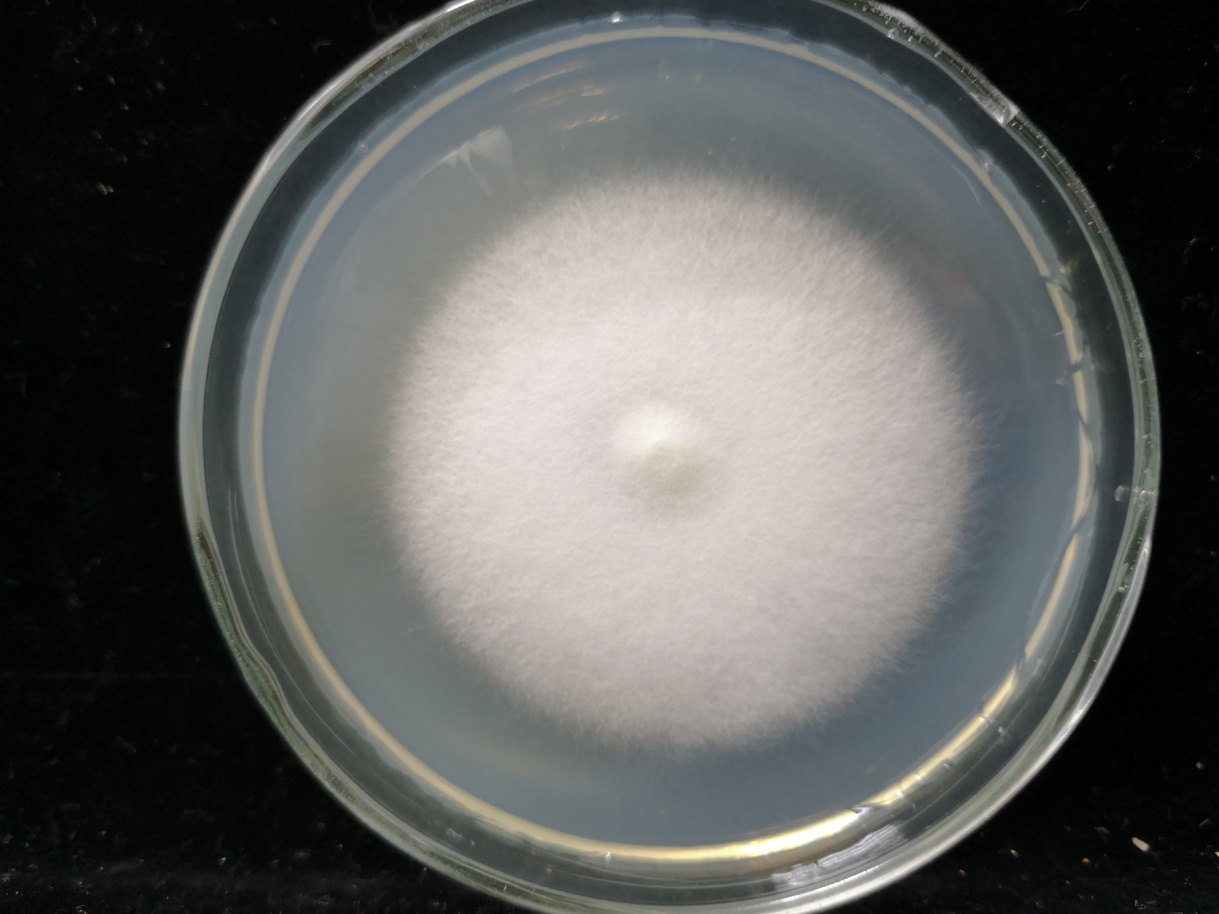
b75621bb1a0a42a28ecb38f1d9b4b8a6.Jpeg

青年人才计划 优秀项目主持人丨王瑞娟:助力金针菇工厂化发展

作为“市级农口系统青年人才成长计划”项目之一,上海市农科院食用菌所王瑞娟主持的《金针菇新品种上研1号高效栽培技术与示范推广》课题最终入选为“成长计划”成果论坛的优秀项目候选。若不是王瑞娟的介绍,相信很多人都不知道,稀松平常的金针菇背后竟凝结着科研人员大量的心血和汗水。
上研1号菌种
“上研1号”化被动为主动
食用菌生产作为一种绿色、环保的生产方式,每年可将500多万吨种养业副产物通过食用菌生产转化为优质食物,并且作为低脂肪高蛋白的健康食品,成为联合国倡导的“”荤一素一菇”的最佳膳食结构的重要组成部分。食用菌产业在我国发展迅猛,工厂化为食用菌生产发展转型的方向,使得工厂化栽培的品种金针菇的产量迅速增长,2017年产量247.9万吨,相当于能够为我们全国的消费者每人每年提供约2.3公斤的新鲜金针菇。与松茸等高价食用菌相比,金针菇因为实现了工厂化生产,“飞入寻常百姓人家”显得更“接地气”。但是,金针菇生产与消费市场繁荣的背后,支撑整个金针菇产业庞大生产体量的最核心的菌种及相关技术长期以来依赖进口,王瑞娟说:“这意味着,我们的金针菇产业长期以来均受制于人。”
与爆炸性增长的体量相比,我国金针菇产业的核心竞争力较弱,国内工厂化栽培使用的主要金针菇菌种绝大多数引自国外,每年还需缴纳高昂的“品种使用费”。科研人员们做个统计,用种成本约占比就达2-3%,且菌种质量不稳定可控,种源与栽培技术均受制于人,选育自主知识产权、高产、早熟、优质的金针菇品种至关重要。
王瑞娟介绍,项目组以金针菇T011菌种为亲本,采用多孢自交技术,构建F2代群体。在F2代群体中,筛选出农艺性状优良、品质稳定、有应用价值的金针菇菌株。经过小试初筛、中试筛选及品种稳定性测试,最终获得了产量高、早熟、商品性状优良、有效原基多、出菇整齐的新菌株“HJ-25”,经过多次的栽培试验,菌株的栽培特性表现稳定,2015年通过上海市新品种认定,定名为“上研1号”。
“上研1号”在金针菇工厂化生产基地进行了多个批次的栽培试验,表现稳产、高产、早熟、抗逆性佳,其中早熟、子实体整齐度高,有效原基多,优质菇比例高的优点相当突出。且与目前市场主流品种相比,其各项技术指标均达到或者超过前者,受到工厂化栽培企业的普遍欢迎。亟需研究与新品种相配套的栽培方法,最大程度发挥新品种的潜力。

工厂化金针菇新品种“上研1号”
栽培技术作为单独的研究课题进行立项
新品种“上研1号”,其核心指标均达到或者超过现有的商业品种,市场推广前景看好。但是在推广的过程中,王瑞娟团队也发现有2大问题亟待解决,概括起来是一个字“种”。首先,金针菇的种性易变异,造成生产的不稳定,因此急需建立可靠的保种技术与制种技术来保证新品种种性稳定。其次,需要开发高效栽培技术,良种良法配套,以发挥新品种最大的栽培潜力,“解决了这些难题,我们的新品种企业才能进行栽培应用。”王瑞娟说,“真的很感谢农委把栽培技术内容作为单独的研究课题进行立项研究,因为之前栽培技术多作为一个大的新品种选育项目的一部分。”
针对金针菇菌种在保藏中难以保持遗传性能相对稳定问题,王瑞娟和团队成员以金针菇新品种“上研1号”为对象,采用四种常规继代培养保藏法,经两年保藏后,观测活化菌株的生长、液体菌种性能指标及工厂化栽培表现,比较不同保藏方法对金针菇种性的影响,建立了稳定、可靠的保藏方法。同时,团队还配套了高效栽培技术要点。对金针菇的工厂化栽培流程进行了梳理,在关键的工艺点建立了标准的操作方法和工艺参数,其中,以生育期的原基形成作为突破口,建立了简单明了的菌种调控手册,方便企业的技术人员学习要点并掌握。

第九届世界食用菌生物学及产品大会口头报告
在稳定的种与高效的种基础上,王瑞娟团队在金针菇栽培企业进行了推广应用,并且与主栽品种进行了对比,在核心关键指标:节能、高产、早熟、优质等方面均有一定的优势。如今,以上海作为新品种研发与生产标准的研发中心,迅速辐射全国的金针菇工厂化栽培企业,累计应用5.87亿瓶,实现了产业化应用,而该课题的内容也作为重要的成果组成部分申请了上海市农科院与上海市2级科技进步奖的奖项。
【课题介绍】金针菇新品种“上研1号”高效栽培技术与示范应用
我国金针菇产量占世界80%以上,但核心品种及技术一直依赖进口。本项目聚焦这一产业瓶颈,取得以下成果:针对菌种易变异难题,建立液氮超低温与继代培养2种菌种保藏方法,能够保持新品种的种性稳定;制定栽培生产的工艺参数,确保生产的稳定、高效运行,并发表研究论文2篇。“上研1号”在工厂化企业推广5.87亿瓶,其早熟特点突出、平均生物学转化率150%以上、A级菇率80%以上,实现了自主品种国内市场占有率“零”的突破,提升了产业核心竞争力。



用户登录